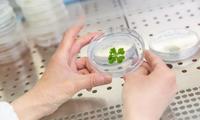

Le aziende europee potranno, in definitiva, sfruttare principi attivi che non derivino da altre zone del mondo, semplificando di molto la produzione di nuovi composti naturali a prezzo più contenuto.
“Questa ricerca apre nuove prospettive per l'innovazione sostenibile, mettendo in luce il potenziale insospettato delle briofite nel promuovere una nuova generazione di prodotti cosmetici e farmaceutici di alta qualità, realizzati con responsabilità e rispetto per l'ambiente” commenta Claudio Varotto, responsabile del progetto e dell’Unità di Ricerca FEM Ecogenomica, finalizzata allo studio della biodiversità vegetale con particolare riferimento a quella dell’ambiente alpino.
Le piante protagoniste del progetto appartengono all'antico gruppo delle briofite, che includono i muschi e le epatiche, queste ultime dalla curiosa forma di un piccolo fegato, da cui il nome assegnato loro dalla comunità scientifica.
I partner, oltre a Fondazione Edmund Mach che ha il ruolo di coordinatore, sono Hub Innovation Trentino (Italia), l’Università di Lund (Svezia), l'Università Jean Monnet (Francia), l’Università Medica di Lublin (Polonia), oltre che diverse ditte europee quali la Bionos Biotech (Spagna), la Plant Advanced technologies (Francia) e la European Science Foundation (Francia).
Articolazione del progetto
Il progetto si articola in più fasi, a partire dalla raccolta in natura e alla coltivazione delle briofite, alle analisi genetiche e del contenuto di composti bioattivi, all’identificazione dei composti a maggior attività, fino alla realizzazione di un documentario e di un sito web per diffondere i risultati sia al pubblico specialista che a quello non specialista.
Oltre a coordinarlo, FEM si occuperà di diverse fasi del progetto. I ricercatori si occuperanno delle raccolte mirate delle briofite che crescono in Trentino, effettueranno le analisi dei geni per la produzione dei composti bioattivi e contribuiranno alla produzione di questi ultimi su larga scala.
(sc)